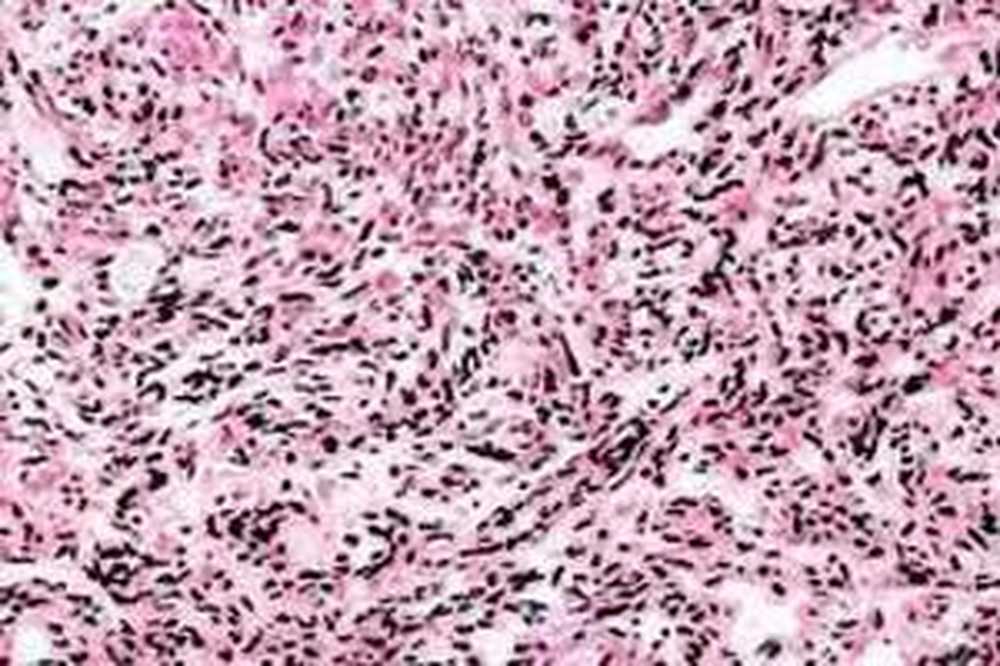

Плеоморфный рак
Как по вину определить цвет краски
Должанская комфорт
В каком городе сша расположен диснейленд
Образующей поверхности
Про орлана
Гороскоп лев 20 августа
Пружина маленькая
Карелия кэмп
Если снится что плачу во сне
Рекуператоры какой выбрать
Феррум лек уколы аналоги
Как правильно сушить боярышник
Английский язык учебник страница 12 номер 3
Плеоморфный рак 113 фото